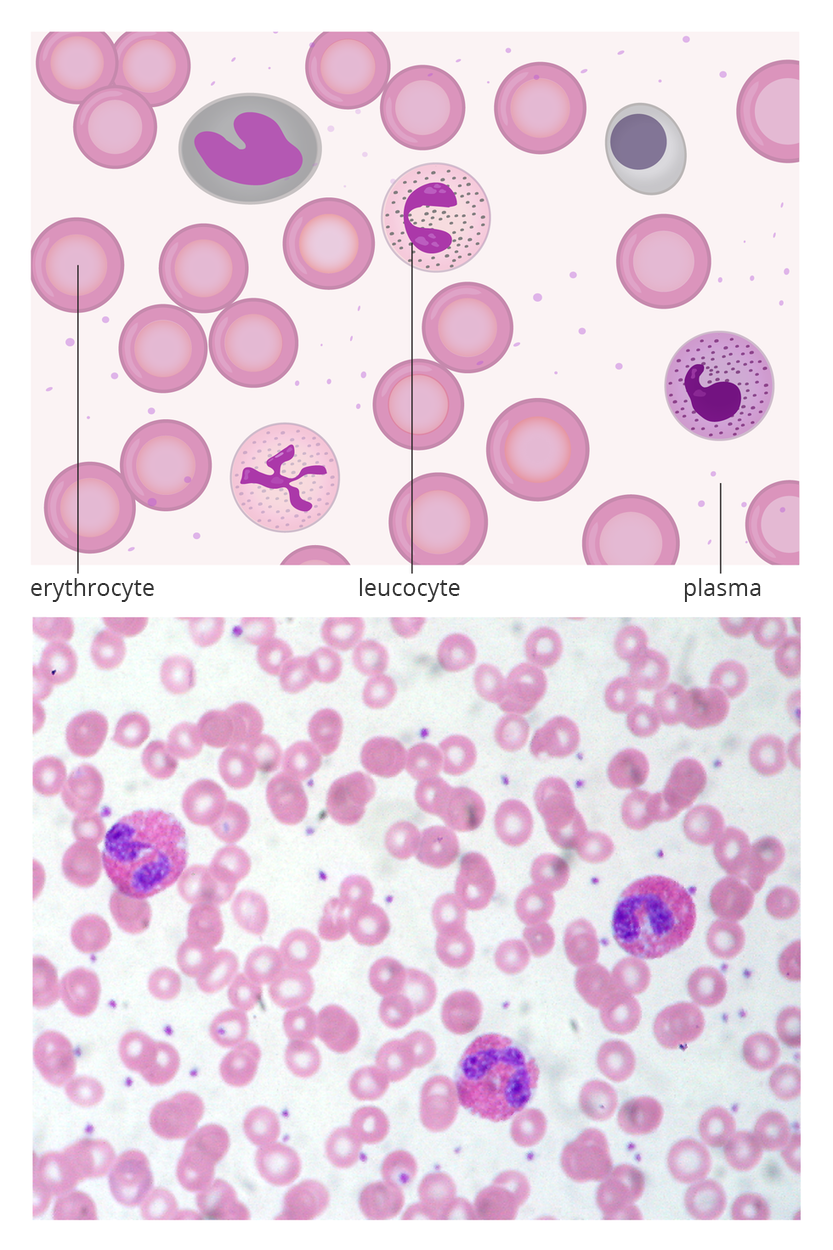
Dwie ilustracje. U góry schematyczny rysunek składników krwi. W jasnym prostokącie kilkanaście okrągłych, różowych komórek z jaśniejszym środkiem, symbolizujących erytrocyty. Okrągłe komórki nakrapiane w środku z rozgałęzionym, fioletowym jądrem to leukocyty. Jasne, kropkowane tło oznaczono jako osocze. Poniżej znajduje się obraz mikroskopowy krwi z licznymi małymi erytrocytami i trzema większymi, ciemniejszymi leukocytami. Podpisano: erythrocyte; leucocyte; plasma

Nervous tissue and connective tissues
a cell is the basic structural and functional unit of an organism;
the animal cell is surrounded by the cell membrane, and in its cytoplasm there are, among others: cell nucleus, mitochondria, endoplasmic reticulum, Golgi apparatus;
a collection of cells with a similar structure, function and origin create a tissue.
to explain what it means that the human body has a hierarchical structure;
to carry out microscopic observations of animal tissues and document them using drawings;
to indicate the relationship of their structure with the function performed (on the example of selected tissues);
to distinguish tissues based on observation of microscopic images and diagrams;
to indicate the features of blood, bone tissue and cartilage tissue proving that they belong to connective tissues group.
Nervous tissue
Nervous tissue is responsible for receiving, analyzing and transferring information. It is composed of neural cells called neuronesneurones, which have a specific shape and which create thick networks or long strands. A neuron usually has a star‑shaped body in which there are cell organelle and 2 types of neural protrusions – dendrites and axons. Dendrites are short, branched structures which receive the neural impulses and conduct them to the body of the neurones. Axons are single, long protrusions which conduct the neural impulses from the body of the cell to other neural cells, called effectors. Effectors are cells or organs of the body that realize the answer to a received stimulus, e.g. skeletal muscles (stimulus – hot iron, effector – muscle that contracts to withdraw the burnt finger).

Between the neurones there are glial cells. These are 90% of the brain cells. They create a cover for the neurones and provide them with nutrients. Last research shows that, besides those functions, at least some part of the glial cells is able to modify the work of neurones. It has also been observed that there is a positive relation between the number of glial cells (called astrocytes) and the plasticity of behaviour of mammals, and, in the case of humans, the imagination and creativity.
Neural cells create the brain and nerves, are found in sensory organs and in skin, and their protrusions reach nearly to all the cells of the body.
Neural cells receive information from the environment. Observe what type of information is registered by the cells in the skin of the cheek.
Connective tissues

Connective tissues are a group of tissues with the greatest diversity. Depending on the structure, they fill free spaces between other tissues and organs, form the core of internal organs and framework of the body, participate in thermoregulation processes, perform reserve function, transport oxygen and nutrients. Depending on the functions performed, the connective tissue cells have different shapes and structures. They are characterised by the ability to produce large amounts of intercellular substance in which they are loosely distributed. The intercellular substance may be hard (mineralised), gelatinous or liquid. It consists of an amorphous basal substance and protein fibres. Due to the structure and function of the connective tissues in the body, we distinguish, among others, adipose tissue, supportive tissue (bone and cartilage) and liquid tissues – blood and lymph.
Adipose tissue is made up of spherical cells, filled with fat which pushes cytoplasm and cell nucleus to the edge of the cell. In addition to being a storage of energy compounds in the form of fat, this tissue protects the body and internal organs against injuries and constitutes a thermal insulation.

Bone tissue is part of the bones that form the framework of the body, support the muscles and protect the internal organs. It is made of a hard, mineralised intercellular substance in which mainly inorganic compounds, such as calcium, phosphorus and magnesium salts, are deposited. Together with the protein fibres, they form bone lamellae that can lay around the blood vessel and nerves running in the canals inside the bones. Bone cells are found between the lamellae.
Cartilage tissue is composed of a jelly‑like, elastic extracellular substance. There are scattered recesses in it – cartilicular cavities in which there are 1, 2 or 3 cartilage cells. Protein fibres occur in the intercellular substance as well, thanks to which the cartilage is elastic (e.g. the cartilage of the ear) and tensile (cartilages of ligaments and tendons). Cartilage tissue often accompanies bones, forming joint surfaces, which facilitates bone movement in the joints. It constitutes a large percentage of the skeleton of young individuals, as well as the framework of organs which must maintain elasticity and flexibility, such as respiratory tract, nose, rib bases.

Explain why a newborn's skeleton (both long bones and, for example, the skull) is mainly made of cartilage tissue, not bone tissue.
The connective tissues that are in motion are blood and lymph. here, the intercellular substance is liquid and consists mainly of water as well as organic and inorganic compounds contained in water. In case of blood, it is called plasma. It contains such cells as: erythrocyteserythrocytes – red cells transporting oxygen from lungs to cells and leucocytesleucocytes – white cells fighting foreign bodies (among others, bacteria and viruses). Apart from them, plasma contains fragments of cells, called thrombocytesthrombocytes or blood platelets, participating in blood coagulation processes.
Analysing the structure, functions and locations of connective tissues, find as many reasons as possible for the names given to them.
Match the pairs: English words with Polish definition.
krwinki czerwone; komórkowe elementy morfotyczne krwi w postaci dwuwklęsłych krążków, pozbawione organelli komórkowych, wypełnione hemoglobiną; uczestniczą w transporcie gazów oddechowych, krwinki białe; komórkowe elementy morfotyczne krwi, które zawierają jądro komórkowe; mają zdolność do pełzakowatego ruchu, uczestniczą w reakcjach obronnych organizmu, komórka nerwowa, zespół komórek o podobnej budowie, funkcji i pochodzeniu, płytki krwi; elementy morfotyczne krwi w postaci fragmentów komórek; uczestniczą w procesie krzepnięcia krwi
| tissue | |
| neuron | |
| erythrocytes | |
| leucocytes | |
| platelets |
Conclusion
The human body has got a hierarchical structure, which can be illustrated as follows: cell – tissue – organ – organ system – organism.
Individual structures of the body cooperate with each other, performing vital functions.
There are 4 types of tissues in the human body: epithelial, muscular, nervous, connective.
The structure of the tissue shows adaptations to the function performed.
Connective tissue fills the spaces between other tissues, has a very diverse structure and function.
How was this lesson? Did you like it? Finish selected sentences.
Sometimes the skeletal and muscular system is described together and called the locomotive system. Find an argument for discussing them together (as one system) and an argument against it.
Keywords
connective tissue, cartilage tissue, bone tissue
Glossary
tkanka – zespół komórek o podobnej budowie, funkcji i pochodzeniu
neuron – komórka nerwowa
erytrocyty – krwinki czerwone; komórkowe elementy morfotyczne krwi w postaci dwuwklęsłych krążków, pozbawione organelli komórkowych, wypełnione hemoglobiną; uczestniczą w transporcie gazów oddechowych
leukocyty – krwinki białe; komórkowe elementy morfotyczne krwi, które zawierają jądro komórkowe; mają zdolność do pełzakowatego ruchu, uczestniczą w reakcjach obronnych organizmu
trombocyty – płytki krwi; elementy morfotyczne krwi w postaci fragmentów komórek; uczestniczą w procesie krzepnięcia krwi